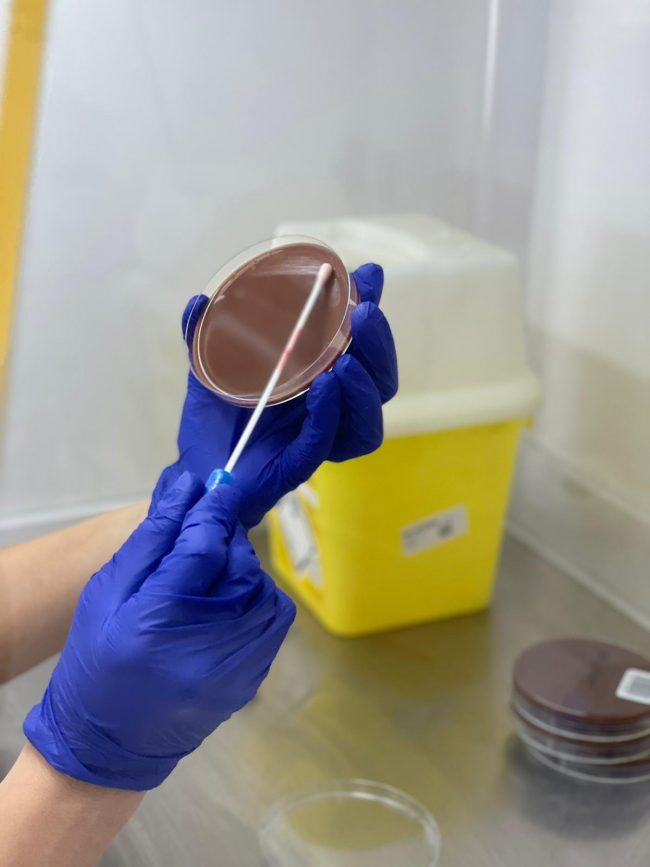
Zenit-cultivo-agar-xocolate

Cada proceso tiene su razón de ser
Cada proceso tiene su razón de ser. En este caso estamos realizando un cultivo microbiológico en agar chocolate. Es el siguiente paso a extraer la muestra. Una vez tenemos el hisopo impregnado con la muestra (órganos, heces, …) lo sembramos en diferentes medios (chocolate, sangre, mc Conkey…). En estas placas crecerán bacterias que aislaremos y…